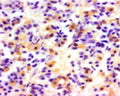

Anti-Luteinizing hormone subunit beta (LH-B) Antibody
Our Anti-Luteinizing hormone subunit beta (LH-B) guinea pig polyclonal primary antibody detects sheep Luteinizing hormone subunit beta (LH-B), and is whole serum. It is validated for use in IHC-Frozen.
The cryostat section of the sheep pituitary was incubated in guinea pig polyclonal antibodies to ovine luteinizing hormone at the dilution of 1:1000 overnight followed by incubation with biotinylated secondary antibodies. Cell bodies and nerve terminals in the sheep brain are intensely stained (brown). This figure shows staining of cells when no pre-absorption is performed.
Click on image to zoom
SKU: GP-036-50
Product Details
Luteinizing hormone subunit beta (LH-B)
Luteinizing hormone promotes spermatogenesis and ovulation by stimulating the testes and ovaries to synthesize steroids. It exists as a heterodimer of a common alpha chain and a unique beta chain which confers biological specificity to thyrotropin, lutropin, follitropin, and gonatropin.
Whole serum
Polyclonal
Mixed
IHC
Guinea Pig
A synthetic peptide corresponding to the antigenic region within the ovine LH residue.
Sheep
Sheep
Spin vial briefly before opening. Reconstitute in 50 µL sterile-filtered, ultrapure water. Centrifuge to remove any insoluble material. Store lyophilized antibody at 2-8°C or lower. After reconstitution, divide into aliquots and store at -20°C, or lower, for optimal long term stability. It is recommended that a reconstituted aliquot is stored at 2-8°C for no longer than 2 weeks. Allocation of an appropriate anti-bacterial agent can increase shelf life by several weeks. Glycerol (1:1) can be added to neat serum for additional stability if intended use does not prevent this.
Lyophilized
Neat serum.
IHC: 1:3000
IHC performed in sheep pituitary demonstrates intense staining of cells. No staining is evident when the primary antibody is pre-absorbed with 0.5 mg/mL of LH.
Unconjugated
Specificity was demonstrated by immunohistochemistry. This antibody is known to react with sheep. Other species have not yet been tested.
For research use only.
United States
12 months after date of receipt (lyophilized, unopened vial).
Lutropin subunit beta [Precursor]; Luteinising hormone subunit beta; LSH-beta; LSH-B; LH-B; Lutropin beta chain; Interstitial cell-stimulating hormone
25°C (ambient)


